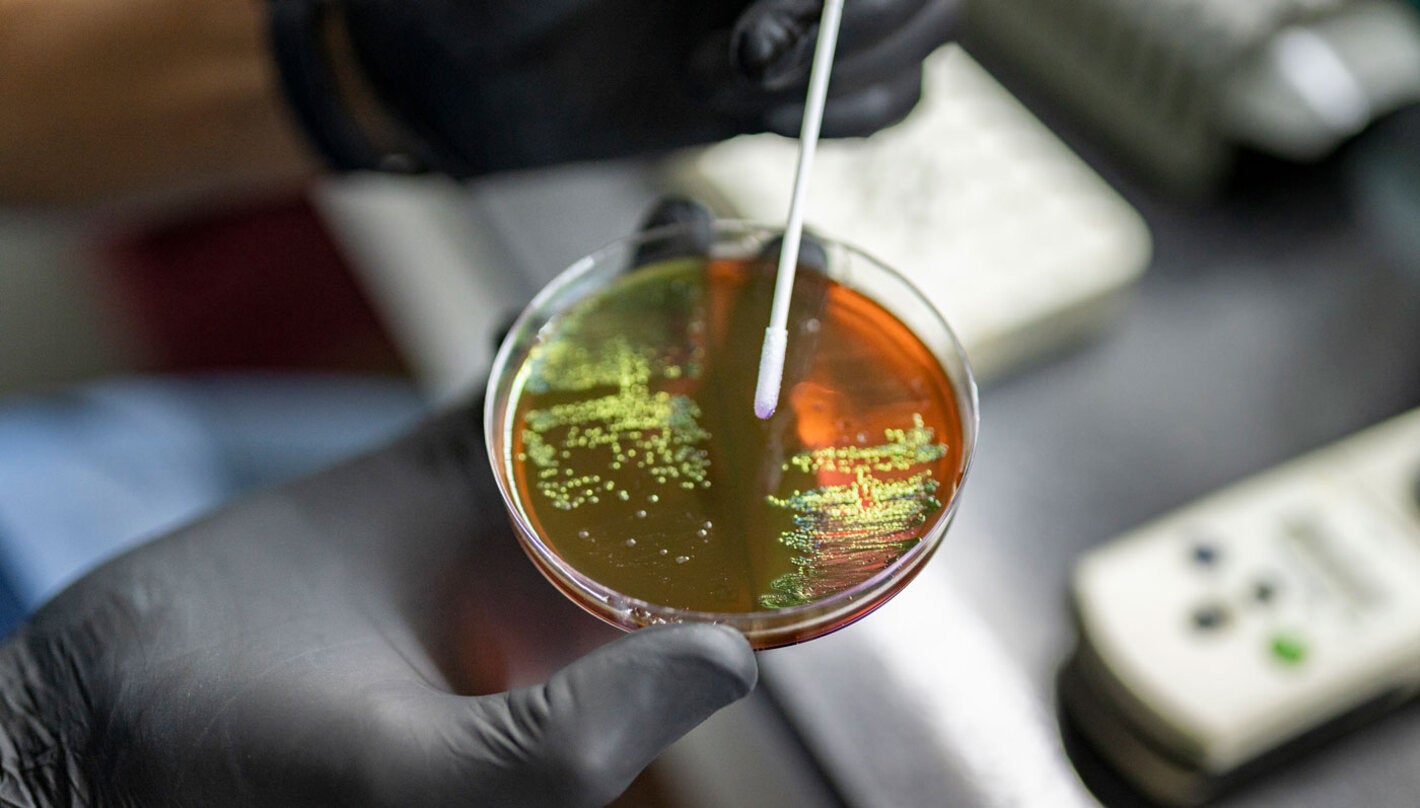
Investigación

25 Ago 2022 — Entender por qué las bacterias se vuelven resistentes a los antibióticos y cómo se presenta esta respuesta ha sido un trabajo fundamental de la mano de los grupos de investigación del país, los cuales, a través de la creación de redes de resistencia, logran tener mapas muy precisos sobre el comportamiento de las tendencias y evolución de la resistencia bacteriana a nivel hospitalario.
Estos datos resultan determinantes, porque su interpretación permite tomar decisiones y definir acciones para luchar contra los microorganismos resistentes.
Muchos de estos grupos de investigación se han convertido en consejeros de primera línea y asesores de los hospitales para la implementación de los Programas de Optimización del Uso de Antimicrobianos (PROA) así como para el mejor aprovechamiento de la plataforma Whonet (de uso gratutito), que permite la notificación de los resultados de la vigilancia epidemiológica a partir de los datos generados por los laboratorios en cada uno de los hospitales.
Esta información es posteriormente exportada y analizada, lo que permite revisar las tendencias de las bacterias más frecuentes en cada una de las áreas del hospital, además de conocer los probables mecanismos de resistencia que estas poseen, para trabajar en la optimización de los antibióticos que deben usarse para lograr una respuesta terapéutica adecuada.
La labor de estas redes tiene muchas aristas positivas. Desde lo científico, han logrado publicar resultados interesantes y valiosos en revistas científicas internacionales, lo que hoy tiene posicionada a Colombia como uno de los líderes en América Latina frente al tema de la lucha contra la resistencia bacteriana.
“Colombia tiene datos propios que son fundamentales, porque uno no puede importar esa información de otros países, ya que las bacterias y, sobre todo, los mecanismos de resistencia son muy diversos. Hemos logrado mostrar lo que hacemos, ser referentes y que se diga ‘mire lo que encontraron en Colombia, mire lo que ellos caracterizaron’, y se ha generado un impacto internacional muy grande”, afirma con orgullo la doctora María Virginia Villegas, médica infectóloga, pionera del tema de investigación en RAM en el país.
Actualmente, la doctora Villegas lidera el Grupo de Investigación en Resistencia Antimicrobiana y Epidemiología Hospitalaria (RAEH), de la Universidad El Bosque (https://investigaciones.unbosque.edu.co/raeh), y asesora varios comités de infecciones en el país: “Comencé la red con ocho hospitales de Cali, Medellín y Bogotá, porque consideré que eran los que podrían tener más problemas de resistencia, pero también los que más estarían dispuestos a trabajar con nosotros, y esa red se fue ampliando hasta tener hoy 35 hospitales en 14 ciudades, unos más activos que otros”, señala.
Cada seis meses analizan cuáles son las bacterias más frecuentes en las diferentes áreas, para que los médicos puedan tomar decisiones de acuerdo al paciente y al área donde está hospitalizado. Además “apoyamos a estos hospitales desde la perspectiva educativa, de identificación adecuada de las bacterias en el laboratorio de microbiología y de prevención, desde los comités de infecciones en cada hospital”, afirma la doctora Villegas.
Otro gran logro de los grupos de investigación en resistencia antimicrobiana ha sido facilitar el conocimiento sobre la magnitud de esta problemática, al aportar desde la academia en investigación y capacitación, como lo resalta la doctora Aura Lucía Leal Castro, especialista en microbiología médica y enfermedades infecciosas, y quien hace 21 años, con un grupo de amigos, docentes y colegas, creó el Grupo para el Control de la Resistencia Bacteriana GREBO (https://www.grupogrebo.org/).
“Pudimos transmitir nuestro conocimiento; lo pusimos al servicio del Sistema de Vigilancia Distrital (Bogotá) y también aportamos en la construcción de lo que es ahora el sistema de vigilancia nacional. Logramos profundizar en temas como la betalactamasa de espectro extendido o conocer a fondo el Staphylococcus aureus, a partir de mirar cómo se diagnosticaba en el laboratorio y de sentarnos a pensar qué debíamos hacer y cómo. Era una necesidad trabajar en el tema, avanzar y aportar desde el laboratorio, el manejo y la prevención”, comenta.
Grandes equipos de trabajo
Un tercer logro ha sido sin duda la formación del talento humano colombiano, no solo desde la labor que se realiza al interior del país, sino por el trabajo colaborativo con otros grupos de investigación, tanto de Latinoamérica como a nivel global, y que ha ayudado a aprender, entender y conocer más esta problemática.
“En nuestro grupo hemos tenido más de seis o siete personas que nos hemos formado desde pequeños, es decir, desde nuestras carreras base (bacteriología, microbiología, biología, medicina) hasta el doctorado, y esto nos ha permitido conocer de manera clara el mapa de la resistencia, pero también generar datos importantes desde la academia”, resalta la doctora Jinnethe Reyes, bacterióloga y magíster en microbiología, directora del Grupo Unidad de Genética de Resistencia Antimicrobiana UGRA de la Universidad El Bosque (https://investigaciones.unbosque.edu.co/ugra).
En su concepto, definitivamente no se puede hacer investigación unitaria o unilateral y, por ello, “ha sido muy importante el apoyo de todas las instituciones, no solamente de la academia, y el aporte de la Organización Mundial de la Salud (OMS), la Organización Panamericana de la Salud (OPS), el Instituto Nacional de Salud (INS), y todo lo que tiene que ver con lograr que lo que hacemos, a partir de la biología molecular, la matemática y la bioinformática, llegue a la gente y lo puedan entender”.
Educar es la clave
Precisamente, otro resultado positivo es ir más allá de los datos, es decir, a la acción, y por eso los grupos de investigación han logrado, además de su trabajo con los hospitales y en los laboratorios de referencia, ‘aterrizar’ las complejidades de la resistencia antimicrobiana y ‘sembrar’ un mensaje en el ciudadano común, para hacerle entender que es parte de la problemática, pero también de la solución.
“Es muy importante conocer las características moleculares de las bacterias responsables de infecciones y cuáles son los mecanismos de resistencia, pero si no adelantamos acciones que impliquen un cambio en la población, no avanzamos. Hemos realizado estudios de conocimientos, actitudes y prácticas y nos dimos cuenta de que tenemos que fortalecer la educación en los profesionales de la salud, no solo en medicina, sino en veterinaria, y trabajar más con la comunidad”, afirma la doctora Judy Natalia Jiménez Quiceno, investigadora senior del Grupo de Microbiología Básica y Aplica MICROBA, de la Escuela de Microbiología de la Universidad de Antioquia, grupo A 1 de MinCiencias, que es la máxima categoría en investigación.
Desde MICROBA comenzaron una interesante estrategia de conocimiento sobre el uso de antibióticos y la resistencia en los colegios (https://www.udea.edu.co/wps/portal/udea/web/inicio/investigacion/grupos-investigacion/ciencias-naturales-exactas/microba). “Ha sido maravilloso porque es impactar a los jóvenes; muchos de los cuales no sabían qué es la resistencia. La pandemia por la COVID-19 nos ha permitido, como un contexto, que conozcan la problemática de las enfermedades infecciosas y que la resistencia bacteriana es como ese enemigo silencioso que está ahí y debemos tomar acciones. Ha sido muy enriquecedor, y nos damos cuenta de que tenemos que seguir trabajando porque hay un desconocimiento enorme”, complementa.
Esta labor de difundir conocimiento y educar ha sido también prioritaria para el sector médico, porque detrás de todo el trabajo en laboratorio, de las pruebas de sensibilidad a los antibióticos, de la estandarización de las mismas, y del apoyo a cada clínica y hospital, hay otra loable tarea: “Brindarle todas las herramientas a los médicos para que tomen la mejor decisión cuando un paciente llega con un proceso infeccioso o está hospitalizado, y esta información que obtenemos es supremamente útil para que puedan hacer una correcta elección de la terapia para cada paciente”, explica el doctor Carlos Gonzalo Robledo Restrepo, médico, microbiólogo, director y fundador del Grupo GERMEN (http://www.grupogermen.org).
Destaca también el doctor Robledo el trabajo colaborativo que se ha logrado en estos años y que ha permitido generar proyectos de investigación sólidos y de gran valor, que se consolidan con las publicaciones científicas y la participación en encuentros de investigadores.
De igual forma, el trabajo multidisciplinar y entre redes ha contribuido ampliamente a fortalecer la vigilancia en diversas áreas y ha permitido la realización de estudios centinela. Uno de ellos es el que realizaron la OMS/OPS, el Ministerio de Salud y Protección Social, el Instituto Nacional de Salud, la Secretaría Distrital de Salud y el Hospital Pediátrico La Misericordia (HOMI) para vigilar las causas de la neumonía y la meningitis bacteriana en los niños menores de 5 años.
Sobre este tema también se han centrado investigaciones del Grupo de Estudio de Enfermedad Neumocócica en Colombia NeumoColombia (neumocolombia@gmail.com), que han permitido caracterizar la enfermedad neumocócica invasiva en el país, encontrando que “el neumococo, una bacteria grampositiva, sigue siendo la primera causa de neumonía en nuestro medio, y hay una tendencia al aumento de la resistencia con los años, debido a múltiples factores”, señala el doctor Germán Camacho Moreno, infectólogo pediatra del HOMI, miembro del Grupo de Investigación de Enfermedades Infecciosas de la Facultad de Medicina de la Universidad Nacional y uno de los coordinadores de la Red NeumoColombia.
En esa búsqueda minuciosa de la realidad de la resistencia antimicrobiana cada día hay más respuestas, retos y desafíos. Hoy, por ejemplo, se habla del impacto de este tema no solo en la salud humana, sino en la sanidad animal, y se está comenzando a explorar el impacto en la parte ambiental.
Así, esto significa que hay grandes esperanzas de poder combatir la resistencia antimicrobiana, porque, coinciden todos los investigadores y sus grupos, en que quieren seguir desde la academia, con apoyo de las sociedades científicas y otros organismos, trabajando en equipo y aportándole al país experiencia, conocimiento, resultados y estrategias.
Para ello tienen propuestas claras, entre otras, evaluar a fondo lo que se ha hecho hasta hoy, incluso las normativas, y sentarse a la mesa para dialogar, dar ideas y buscar las mejores soluciones para afrontar esta problemática y seguir tras el rastro de las bacterias multirresistentes.



